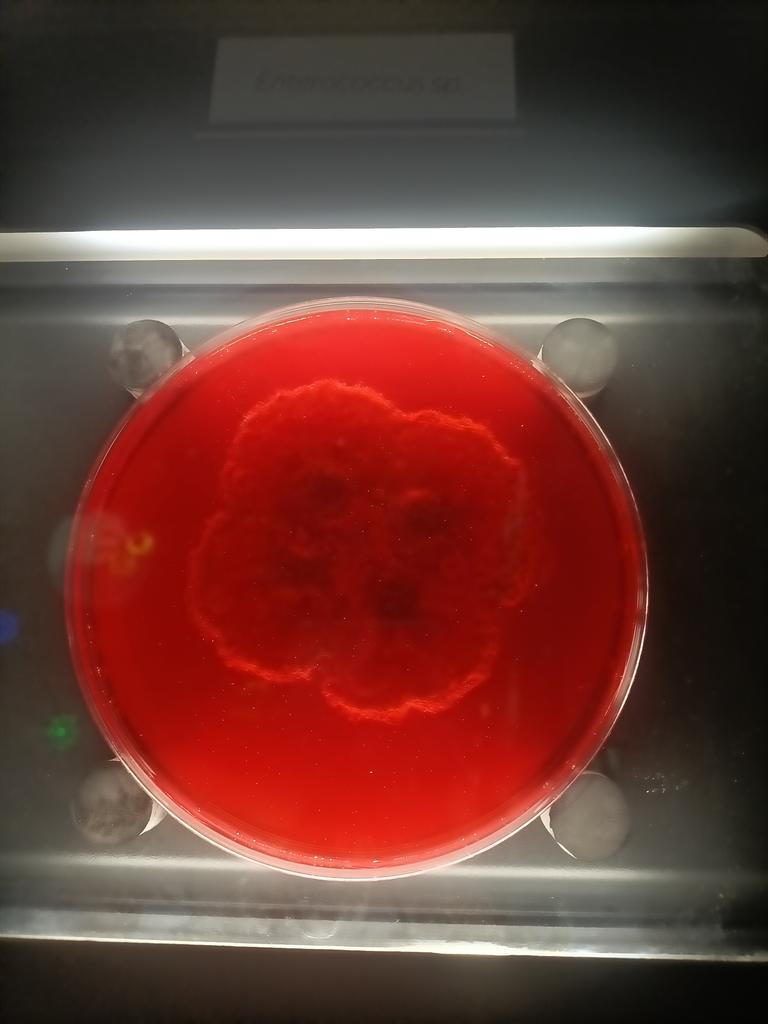
Valérie Ferreras tweet media

Félicitations aux élèves du BTS MECP de Castres. 3 labels au salon de la micro entreprise @EPAOccitanie . Label créativité, impact local, artisanat. @actoulouse @BordeBasse #castres #biotechnologies #btsmecp




Français
BTS MECP Castres
48 posts

@BTSMECPCastres
BTS MECP option cosmétologie. Les produits comsétiques, création et imagination